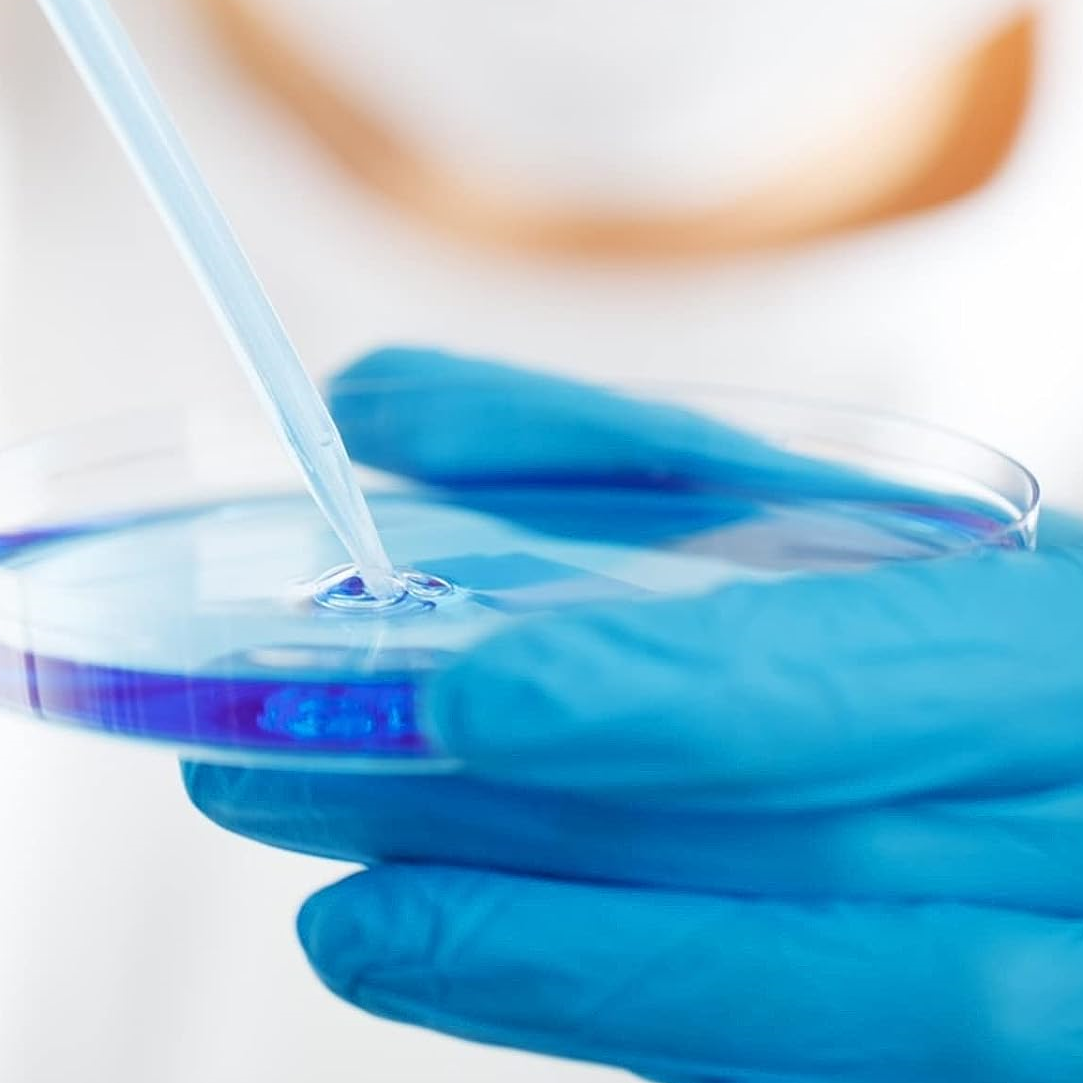

Toronto, Ontario, Canada
200,000 ft² | 18,580 m²
The planning of this six phase move through the busy Toronto, Ontario downtown core was complex and involved immense detail and manpower for Health Care Relocations. The first phase was completed in December when the entire Toronto Medical Research library was moved. Over the course of the next few months, a total of 47 research labs and multiple office space moves were logistically planned and executed from the Mars Building and the University Of Toronto Medical Research Building to the new Keenan Research Centre & Li Ka Shing Knowledge Institute of St. Michael’s.